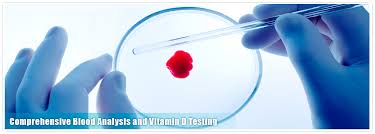

Chỉ điểm sinh học khối u
Đại cương
Chỉ điểm khối u (tumor marker) là những chất được sinh ra bởi các tế bào ung thư hoặc tế bào không ung thư trong quá trình đáp ứng với các tình trạng ung thư. Các chỉ điểm này thường sinh ra một lượng cao hơn trong bệnh lý ung thư và có thể phát hiện chúng trong các mẫu bệnh phẩm máu, nước tiểu, phân, mô và dịch cơ thể.
Phát hiện các chất chỉ điểm khối u đã trở thành một phương pháp quan trọng được ứng dụng rông rãi trong việc sàng lọc, phát hiện sớm, đánh giá kết quả điều trị, tiên lượng bệnh và theo dõi sự ổn định sau khi điều trị của nhiều loại ung thư.
Theo thống kê của Tổ chức Y tế thế giới, tỉ lệ chất hàng năm do ung thư tăng lên nhanh kể từ đầu thế kỷ đến nay. Nhiều quốc gia cho thấy ung thư là nguyên nhân gây tử vong đứng thứ hai sau bệnh tim mạch. Nguy cơ người bị ung thư tăng lên theo lứa tuổi và tình trạng phát triển công nghiệp ở mỗi quốc gia. Theo ghi nhận của Bộ Y tế về mô hình bệnh tật ở nước ta, bên cạnh các bệnh nhiễm khuẩn, suy dinh dưỡng ngày càng được khống chế, giảm dần, thì mô hình bệnh ung thư, bệnh tim mạch, tâm thần đang là nguy cơ giống như ở các nước phát triển.
Trong khi ở nhiều nước, chương trình sàng lọc phát hiện sớm ung thư rất phát triển góp phần chữa khỏi hơn 50% bệnh nhân ung thư (có loại lên tới trên 90% như bệnh Hogdkin, trên 80% đối với ung thư thân tử cung). Ở nước ta đa số người bị ung thư khi được chẩn đoán đã ở giai đoạn muộn, tỷ lệ khỏi bệnh rất thấp.
Ngày nay, y học ngày càng có nhiều kỹ thuật và quy trình chẩn đoán, phát hiện sớm ung thư. Phát hiện các chất chỉ điểm khối u đã trở thành một phương pháp quan trọng được ứng dụng rông rãi trong việc sàng lọc phát hiện sớm, đánh giá kết quả điều trị, tiên lượng bệnh và theo dõi sự ổn định sau khi điều trị của nhiều loại ung thư.

H1
Nhờ vào việc ứng dụng kháng thể đơn dòng để đo lường một số lượng các chỉ điểm khối u có giá trị trong chẩn đoán hay tiên lượng bệnh ung thư. Chỉ điểm ung thư có một vai trò quan trọng trong việc phát hiện sớm một số khối u trước khi có triệu chứng lâm sàng xuất hiện. Chất chỉ điểm khối u có thể ứng dụng để sàng lọc bệnh nhân, có thể chẩn đoán và tiên lượng bệnh nhân đang điều trị, một số khác để theo dõi di căn ung thư.

H2
Khái niệm về chất chỉ điểm khối u
Các chất chỉ điểm khối u là những đại phân tử xuất hiện và thay đổi nồng độ trong cơ thể sống, có liên quan tới sự phát triển các khối u ác tính của cơ thể đó. Về phân loại, có hai loại chỉ điểm khối u: Chỉ điểm tế bào: là các kháng nguyên tập trung trên bề mặt màng tế bào như trong bệnh ung thư máu, các nội tiết tố và cơ quan thụ cảm nội tiết trong ung thư vú. Chỉ điểm dịch thể: là những chất xuất hiện tập trung trong huyết thanh, nước tiểu hoặc các dịch khác của cơ thể. Các chất này được tổng hợp và bài tiết từ mô khối u, được giải phóng nhờ sự phân hủy tế bào u hoặc được tạo thành như là sự phản ứng của cơ thể đối với khối u.
Tiêu chuẩn của các chất chỉ điểm khối u
Chất chỉ điểm khối u lý tưởng cần có các tiêu chuẩn sau: Tính đặc hiệu cao, tính nhạy cao; Không phát hiện thấy trong bệnh nhân lành tính và người khoẻ mạnh; Có thể phát hiện rất sớm, từ khi chỉ có vài tế bào ung thư xuất hiện; Đặc hiệu cho từng cơ quan, tương quan với giai đoạn của khối u; Có giá trị dự đoán tin cậy. Hiện nay, chưa có chất chỉ điểm khối u lý tưởng có đầy đủ 100% tiêu chuẩn về độ nhạy, độ đặc hiệu, độ tin cậy chắc chắn, tính đặc hiệu cơ quan và chẩn đoán chính xác giai đoạn bệnh. Tuy nhiên, một loại chỉ điểm khối u có những giá trị trên các tiêu chuẩn khác nhau và khi phối hợp 2 hay nhiều thử nghiệm lại, kết hợp với triệu chứng trên lâm sàng sẽ thêm giá trị bổ sung chẩn đoán. PSA, PAP’s và thyroglobulin là những chất chỉ điểm đặc hiệu cho cơ quan có u.

H3
Nhiều chỉ điểm khối u có tương quan với giai đoạn phát triển u, có nồng độ tăng cao ở những giai đoạn muộn. Tuy khó xác định chắc chắn khối u đang ở giai đoạn nào và đôi khi có sự trùng chéo giữa các loại. Tuy nhiên, giá trị tiên lượng của một số chất chỉ điểm rất rõ và thường gắn với quá trình tiến triển và kết quả điều trị (chẳng hạn, hàm lượng C.E.A trước mổ ung thư đại trực tràng, β2 microglobulin trong u lympho ác tính không Hogdkin và bệnh đa u tủy xương; C.A-125 trong ung thư buồng trứng càng cao thì tiên lượng càng xấu, khả năng tái phát, di căn càng nhiều)
Độ nhạy và độ đặc hiệu của một chất chỉ điểm được tính bằng:
Độ nhạy (Se) = Số lần (+) thật/ Số lần (+) thật + Số lần ( - ) giả.
Độ đặc hiệu (Sp) = Số lần (-) giả)/ Số lần (-) thật + Số lần (+) giả.
Một số tiêu chuẩn quan trọng khác là các giá trị dự đoán gồm có giá trị dự đoán dương tính: khả năng có một khối ung thư nào đó xuất hiện mà có thể sử dụng 1 phức hợp các nghiệm pháp kiểm tra phát hiện được. Giá trị dự đoán âm tính: chỉ ra rằng không thể có một loại u ng thư nào đó xuất hiện nếu kết quả xét nghiệm âm tính.
Giá trị dự đoán (-) = Số lần (-) thật/ Số lần (-) thật + Số lần (-) giả.
Giá trị dự đoán (+) = Số lần (+) thật/ Số lần (+) thật + Số lần (+) giả.

H4
Ứng dụng lâm sàng của chỉ điểm khối u
-Trong sàng lọc: Các chất chỉ điểm khối u sẽ không thích hợp dùng trong sàng lọc các nhóm chưa có triệu chứng nếu độ đặc hiệu và độ nhạy của test quá thấp. Trái lại, có thể dùng sàng lọc cho những nhóm người có nguy cơ cao. Ví dụ: α FP đối với bệnh nhân xơ gan có nhiều nguy cơ mắc ung thư gan nguyên phát; calcitonin đối với nhóm người trong những gia đình có tiền sử ung thư tuyến giáp;
-Chẩn đoán ban đầu: Thông thường ứng dụng này ít được sử dụng vì thiếu độ đặc hiệu và độ nhạy. Kết quả âm tính giả thường không có giá trị phủ định. Những chất chỉ điểm khối u sau có thể được sử dụng để chẩn đoán ban đầu βhCG, αFP và calcitonin;
-Xác định cơ quan có khối u: PSA hoặc PAP tăng cao trong bệnh u tuyến tiền liệt, thyroglobulin tăng cao trong ung thư tuyến giáp, sau phẩu thuật cắt tuyến giáp nếu thyroglobulin tăng trở lại chứng tỏ bệnh tiến triển;
-Xác định giai đoạn: Một vài chất chỉ điểm khối u có nồng độ liên quan đến giai đoạn bệnh (số lượng tế bào u nguyên phát và di căn). Ví dụ như C.E.A trong ung thư đại trực tràng;
-Tiên lượng bệnh: Một số chất chỉ điểm khối u có giá trị tiên lượng, độ tập trung cao có giá trị tiên lượng xấu. Đo giá trị trước và sau điều trị sẽ có thể biết tiên lượng của bệnh. Ví dụ chất C.E.A, β2-microglobulin, C.A 15-3;
-Kiểm tra điều trị và theo dõi: đó là chỉ định quan trọng nhất của chất chỉ điểm khối u, là cách kiểm tra hiệu quả nhất các kết quả điều trị bằng phẫu thuật, tia xạ, hoá chất. Các chỉ điểm khối u trở về mức bình thường chứng tỏ đã lấy đi hết hoặc thoái lui toàn bộ khối u. Tồn tại dai dẵng ở mức bệnh lý hoặc tăng lên sau thời gian ngắn xuống dốc chứng tỏ bệnh vẫn còn tồn tại hoặc có di căn. Tăng lên trở lại sau khi đã ổn định ở mức bình thường, chứng tỏ bệnh tái phát.

H5
Nhìn chung, hiện nay chúng ta dùng chỉ điểm khối u là để theo dõi đáp ứng điều trị ung thư đặc biệt và chẩn đoán khi có nghi ngờ. Một số kháng thể đơn dòng được sử dụng để theo dõi, đo lường chỉ điểm khối u và có mục đích hỗ trợ chẩn đoán.
Bảng Tóm tắt các chỉ điểm khối u giúp phát hiện, chẩn đoán ung thư
TT | Chất chỉ điểm | Cơ quan liên quan | Nồng độ Bình thường | Chỉ số cảnh báo |
1 | AFP (1) (alpha Feotoprotein) | Gan, tinh hoàn, phôi thai, dạ dày | NL: 0,57-6,85 IU/ml TE: 1,9-7,1 IU/ml | > 200 IU/ml |
2 | CEA (2) Carcino- embryonic antigen) | Phổi, đại tràng, vú và tuỵ | 0,17-4,26 ng/ml | Người BT 5 ng/ml. (5) |
3 | CA-72-4 Cancer Antigen 72-4) | Dạ dày, tế bào tiết nhầy buồng trứng không tăng CA 125 | 1,35-3,15 U/ml | > 4 U/ml ? (độ nhạy thấp) |
4 | CA 19-9(3)(Cancer Antigen 19.9) | Tuỵ | 0-29,56 U/ml | 37 U/ml ? |
5 | CA 15.3 (Cancer Antigen 15-3) | Vú | 2,14-28,34 U/ml | > 30 U/ml (+) giả trong viêm tuỵ, viêm gan, bệnh lý vú lành tính) |
6 | CA 125 (Cancer Antigen 125) | Buồng trứng | £ 35 U/mL | 65 U/mL |
7 | Calcitonin | Ung thư tuyến giáp | < 10-50 pg/mL | 100-150 pg/mL |
8 | PSA, fpSA/PSA(4) (Prostatic Specific Antigen) | Tuyến tiền liệt | 0-4 ng/mL, | 10 ng/mL |
9 | bHCG (Human Choriocarcinoma Gonadotropine) | -Tế bào nuôi hoặc tinh hoàn, một số tác giả dựa vào kinh nghiệm, trong thử thai có giá trị 25mUI/ml (thường xét nghiệm sau ngày 14 sau chuyển phôi); -Đánh giá tiên lượng, đáp ứng điều trị. |
10 | N.S.E (Neuron specific enolase)(6) | U nguyên bào thần kinh, K phế quản, song chưa có dữ liệu rõ ràng đủ minh chứng |
11 | 5-HIA.A (5-Hydroxy Indoleacetic Acid) | Hội chứng ung thư, ít phổ biến vì phương tiện và hoá chất. |
12 | SCC-TA4 (Squamouscell carcinoma) | Phân lập từ ung thư tế bào gai cổ tử cung, giúp theo dõi điều trị tái phát ung thư tế bào gai, xếp loại mô học ung thư màng phổi. Kết quả (-) trong 50% ca. |
13 | Protein gamma AP2 | Chỉ điểm phát hiện sớm ung thư tinh hoàn, hiện chưa có số liệu rõ ràng để công bố chính thức. |
14 | 5-HIA.A (5-hydroxy indoleacetic acide) | Có mặt trong hầu hết các hội chứng ung thư nói chung |
15 | CA 27.29 | Rất quan trọng để phát hiện K vú tái phát, nhưng phần lớn người ta dùng để theo dõi điều trị và theo dõi di căn. |
16 | β2-microglobulin | -Phát hiện chẩn đoán bệnh đa u tủy lympho non-Hodgkin, bệnh bạch cầu lympho mạn tính và một số loại u lympho khác; -Bệnh phẩm gồm máu, nước tiểu hay dịch não tủy. chỉ điểm này còn dùng theo dõi đáp ứng điều trị và tiên lượng |
17 | CA 72-4 | Ung thư dạ dày, hay ung thư buồng trứng |
18 | DR-70 | Giúp sàng lọc và chẩn đoán nhiều loại ung thư, nhạy nhưng không đặc hiệu nên khi dương tính, cần phải phối hợp các kỹ thuật chẩn đoán hình ảnh bổ sung chẩn đoán như PET-CT hay siêu âm. |
19 | BRCA1 và BRCA2 | -Đánh giá và theo dõi đáp ứng điều trị ung thư vú bởi liệu pháp đích; -Mẫu bệnh phẩm lấy là máu. |
20 | Đột biến BRAF V600 | -Đánh giá u sắc tố melanoma dưới da và ung thư đại trực tràng; -Mẫu bệnh phẩm cần là sinh thiết mô. Có thể giúp bệnh nhân phù hợp với một số liệu pháp điều trị. |
21 | C-kit/CD117 | -Đánh giá ung thư tiêu hóa, u melanoma niêm mạc; -Giúp chẩn đoán và xác định điều trị thông qua lấy mảnh mô sinh thiết. |
22 | CA15-3/CA27.29 | -Đánh giá phát hiện và diễn tiến điều trị ung thư vú; -Mẫu bệnh phẩm là máu. |
23 | Nhiễm sắc thể 3, 7, 17, và 9p21 | -Đánh giá ung thư bàng quang bằng nước tiểu; -Giúp giám sát tái phát khối u |
24 | Phân tích đột biến gen EGFR | -Đánh giá ung thư phối tế bào không nhỏ; Xác định điều trị và tiên lượng. |
25 | Lactate dehydrogenase (LDH) | -Đánh giá ung thư tế bào mầm, lymphoma, leukemia, melanoma và neuroblastoma; -Bệnh phẩm là máu, giúp đánh giá giai đoạn ,tiên lượng và theo dõi đáp ứng điều trị. |
26 | Thyroglobulin | -Đánh giá ung thư tuyến giáp, bệnh phẩm là máu; -Dùng để đánh giá đáp ứng điều trị và sự tái phát. |
(1) AFP là một loại protein do gan tổng hợp ở bào thai, khi ra đời thì gan ngưng sản xuất, hàm lượng tăng trong ung thư gan nguyên phát, viêm gan cấp và mạn tính, xơ gan, ung thư tinh hoàn, đường tiêu hoá, buồng trứng, phụ nữ mang thai với thai bị di tật, nhất là tật vô sọ, nứt đốt sống;
- Định lượng lúc sản phụ được 16 tuần nếu tăng thì chỉ định chọc ối: bình thường ở máu sản phụ tăng từ tuần thứ 10, sau đó giảm dần. Tại nước ối, hàm lượng tăng tối đa tuần thứ 12-14, sau đó giảm dần.
- Với ung thư buồng trứng, được xem là kẻ giết người thầm lặng vì triệu chứng bệnh không biểu hiện cho đến lúc bệnh vào giai đoạn muộn. Hiện tại, trên thế giới có một bộ xét nghiệm để phát hiện sớm, khi so sánh mẫu máu của 150 bênh nhân bị ung thư buồng trứng và 150 bệnh nhân bình thường, các nhà nghiên cứu bệnh viện Jonhs Hopkins (Baltimore, USA) đã phát hiện ra 3 loại protein: Transthyretine, ITIH4, Apolipoprotein A1 là các chỉ điểm ung thư buồng trứng và cả 3 protein này đều có mặt ngay giai đoạn đầu của bệnh. Test này có độ nhạy và đặc hiệu gần 99% và độ chính xác 83%, hoặc một nghiên cứu khác của trường y khoa thuộc đại học Yale (Mỹ) đã đưa ra một phương pháp xét nghiệm có thể giúp phát hiện ung thư buồng trứng trong giai đoạn sớm, nhằm nâng cao chẩn đoán và điều trị sớm cho bệnh nhân. phương pháp chủ yếu dựa trên xét nghiệm các chất như leptin, prolactin, osteopotin trong máu và thử nghiệm đạt độ chính xác đến > 95%;

H6
(2) CEA thuộc nhóm kháng nguyênthời kỳ phôi thai và mất đi sau sinh. Xuất hiện lại trong ung thư đường tiêu hoá, tăng trong ung thư đại tràng, tuỵ, vú, viêm gan do rượu, viêm ruột, nghiện thuốc lá, polyp ruột già, suy thận. Nên kết quả có thể dương tính giả trong các bệnh lý đó;
(3) CA19.9 phối hợp với C.A.E giúp chẩn đoán ung thư hệ tiêu hoá, theo dõi điều trị tái phát trong ung thư tế bào tiết nhầy của buồng trứng khi CA15.3 không tăng. Sự tăng khác nhau về giá trị giúp chẩn đoán phân biệt ung thư tuỵ và viêm tuỵ cấp. Dương tính giả trong viêm tuỵ cấp, viêm gan mạn, tắc đường mật;
(4) Chỉ số PSA tăng theo tuổi, khoảng 10-20% ung thư tiền liệt tuyến có PSA bình thường (khoảng 25-45%). Bình thường PSA theo phương pháp định lượng huỳnh quang miễn dịch < 2,5ng/ml. Nếu cao hơn chỉ số đó phải nghi ngờ, nhất là khi trên 10ng/ml. Còn giữa 2,5-10ng/ml cần phải làm sinh thiết nhiều nơi ở vùng giảm âm hoặc là khi tỷ số PSA không phù hợp tương ứng với thể tích tiền liệt tuyến. Ngược lại, nếu âm tính PSA phù hợp, cần làm lại PSA sau 6 tháng và nếu giá trị tăng, cần làm sinh thiết nhiều nơi. Theo Stamey, PSA còn liên quan đến thể tích của tiền liệt tuyến: 0,3 ng/ml tương ứng với 1g tổ chức tiền liệt tuyến (ví dụ tổ chức tiền liệt tuyến 30 g thì về lý thuyếtPSA phải là 9 ng/ml).
Nếu dùng phương pháp thăm dò trực tràng bằng kỹ thuật số hoặc siêu âm cắt ngang với xét nghiệm trên sẽ có giá trị chẩn đoán tin cậy hơn. Ngoài ra, một số bệnh phì đại tuyến hay viêm tuyến này cũng cho trị số PSA cao. Bất thường về PSA hoặc khám nghiệm trực tràng bằng kỹ thuật số cùng với siêu âm xuyên qua trực tràngvà sinh thiết nếu có thể, sẽ có được một chẩn đoán chính xác hơn đối với một trường hợp nghi ngờ ung thư tiền liệt tuyến. Chỉ số PSA phải được đánh giá một cách chi tiết và cân nhắc vì trong trường hợp tăng sinh lành tính phì đại và viêm tuyến tiền liệt cũng tăng chỉ số này.
H7
Trong các trường hợp tăng sinh lành tính thì trị số này nằm trong khoảng 4-10ng/mL. Ngược lại, nếu PSA lớn hơn 10ng/mL thì nghĩ đến ung thư.Ngoài ra, khoảng 25-45% ca ung thư tiền liệt tuyến có giá trị PSA bình thường.
Song để chẩn đoán đáng tin cậy nên phối hợp một số thủ thuật cận lâm sàng khác như khám chuyên khoa niệu, xét nghiệm PSA máu, siêu âm nội trực tràng, đo niệu dòng đồ, lượng nước tiểu tồn lưu sau khi đi tiểu hết.

H8
Một thử nghiệm do các nhà khoa học ở đại học Duke (Mỹ) tiến hành nhằm đánh giá hiệu lực trì hoãn sự tái phát bệnh ung thư tuyến tiền liệt củaa một loại vaccin mới. Trong nghiên cứu này, các tế bào bạch cầu của chính bệnh nhân đã được sử dụng để hoạt hoá hệ thống miễn dịch, liên kết các kháng nguyên telomerase - một chất do các tế bào ung thư tiết ra, với các tế bào T của cơ thể.
Kết quả cho thấy, trong số 20 bệnh nhân, có 19 trường hợp gia tăng tế bào T chống telomerase. Trong 9 bệnh nhân, các tế bào bạch cầu được biến đổi về phương diện di truyền thấy có tăng CD4. Tất cả đều gia tăng đáp ứng miễn dịch. Ngoài ra, các nhà nghiêncứu còn cho thấy, tiêm chủng đã làm giảm các tế bào u và làm chậm sự gia tăng nồng độ PSA, nó còn cho phép phân biệt các tế bào bình thường với tế bào ung thư, do đó có thể giúp loại trừ được các tế bào khối u ở người bệnh.

H9
Việc chẩn đoán u lành tiền liệt tuyến, khi khám phát hiện có dấu hiệu phì đại tiền liệt tuyến (mềm và đồng nhất), không nên kết luận ngay là u lành mà phải làm xét nghiệm PSA, bởi lẽ trên thực tế hơn 50% nam giới không được đề nghị đo PSA, điều này dễ dẫn đến bỏ sót ung thư tuyến này. Theo Hiệp hội ung thư Mỹ khuyến cáocần làm PSA một lần/ năm cho đàn ông tuổi từ 50-75 và cho những người trên 45 tuổi có thân nhân bị ung thư tuyến tiền liệt. PSA bình thường khoảng 4 ng/ml, nhưng nó có thể thay đổi tuỳ thuộc vào kỹ thuật đo. Do vậy, không nên thay đổi nơi xét nghiệm để tiện theo dõi diễn tiến bệnh.
(5):Với người nghiện thuốc lá là 10 ng/ml.
(6):Đây là một isoenzym của endolase tham gia phân huỷ đường glucose, giúp theo dõi điều trị, phát hiện tái phát u nguyên bào thần kinh, xếp phân loại tế bào mô học- là chất đánh dấu tế bào nhỏ. Dương tính giả khi có tán huyết.

Hình Mô tả vị trí ung thư, chỉ điểm khối u và thời gian thực hiện xét nghiệm
Với ung thư tinh hoàn, gần đây các nhà nghiên cứu Đan Mạch đã phát hiện ra một loại protein đặc hiệu cho việc phát hiện sớm ung thư tinh hoàn, đó là protein đặc hiệu gamma AP2 trong tinh dịch của bệnh nhân ung thư, nhờ marker này người ta phát hiện ung thư tinh hoàn giai đoạn sớm. Chỉ điểm khối u này nhạy cảm hơn PAP (photphate acide prostatique). Nếu phối hợp 2 chỉ điểm trên sẽ phát hiện tốt di căn xương hoặc hạch với độ nhạy cao. Lưu ý chỉ đo thông số PSA thời điểm 8 ngày sau khi thăm trực tràng.
Trong bảng trên cho thấy các giá trị xét nghiệm có thể thay đổi tùy thuộc vào từng phương pháp xét nghiệm. Các ngưỡng này đưa vào khung chẩn đoán ung thư chưa được thống nhất giữa các nhà lâm sàng và ung thư. Gần đây, các nhà nghiên cứu đã điều chỉnh các test phát hiện ung thư kết tràng, phối hợp tìm máu ẩn trong phân và nội soi ống soi mềm để kiểm tra khối u xâm lấn (nếu có).

H10
Giá trị thông số CRP
Đại cương
CRP là một glycoprotein được gan sản xuất có đặc điểm là kết hợp với polysaccharide C của phế cầu, bình thường không thấy protein này trong máu. Tình trạng viêm cấp với phá hủy mô trong cơ thể sẽ kích thích sản xuất protein này và gây tăng nhanh nồng độ protein phản ứng C trong huyết thanh, thường thấy trên các bệnh nhân mắc bệnh tim nặng và nhiễm trùng cấp. Sở dĩ có tên CRP vì nó tủa polysaccharid-C của Streptococcus sp.

H11
Trên người bình thường, xét nghiệm CRP là xét nghiệm định lượng, bình thường chỉ có ở dạng vết (dưới 0,3 mg/100ml huyết thanh hoặc 7-820 mcg%). Nhưng nếu bị viêm nhiễm hay tổn thương cơ quan, chỉ số CRP này có thể được nhân lên đến 1000 lần. CRP có mặt và có thể biểu hiện trongmảng xơ vữa, tạo điều kiện xuất hiện huyết khối, làm tắc/ nghẽn động mạch vành.
Tỷ lệ CRP trong máu giảm song song với giảm LDL-cholesterol trong máu. Nghiên cứu đa trung tâm tại Mỹ đã xác định bệnh nhân có LDL-cholesterol trong máu giảm dưới 70 mg/100ml ít bị tái phát bệnh tim, nếu CRP giảm dưới 2mg/100ml thì nguy cơ tái phát cơn nhồi máu cơ tim giảm. Ngoài ra, CRP còn tăng trong các bệnh nhiễm trùng (vi khuẩn, virus, ký sinh trùng, thấp khớp cấp, Lupus ban đỏ hệ thống). CRP thường tăng trong các viêm nhiễm thuận chiều với chỉ số tốc độ máu lắng tăng và mất khi bệnh khỏi hoàn toàn.

H12
Lợi ích của xét nghiệm CRP
CRP thường sẽ tăng trong vòng 6 giờ kể từ khi có tình trạng viêm, điều này cho phép xác định tình trạng viêm sớm hơn nhiều so với khi sử dụng tốc độ máu lắng. Giá trị của CPR không bị ảnh hưởng bởi sự thay đổi nồng độ globulin máu và hematocrit nên có giá trị khi nồng độ globulin hoặc hematocrit máu thay đổi.
Chỉ định xét nghiệm CRP thường rộng, tuy nhiên lưu ý đây là một xét nghiệm không đặc hiệu, một số chỉ định do bác sĩ lâm sàng xét nghiệm CRP gồm:
-Đánh giá một nhiễm trùng mới như trong viêm ruột thừa và các tình trạng sau mổ;
-Đánh giá mức độ tiến triển phản ứng viêm, nhất là đổi với bệnh lý mãn tính như viêm ruột, viêm khớp;
-Theo dõi đáp ứng điều trị của các bệnh nhiễm trùng, đặc biệt do vi khuẩn.

H13
Giá trị lâm sàng
Trên thực tế giá trị cả thông số CRP có liên quan đến bệnh lý tim mạch, nhiễm trùng và các rối loạn chuyển hóa trong cơ thể.
-Giá trị bình thường: 0 -10 mg/dl hay < 10mg/L;
-Tăng nồng độ protein phản ứng C (CRP) gặp trong: viêm tụy cấp, viêm ruột thừa, nhiễm trùng do vi khuẩn, bỏng, tăng nguy cơ bị ung thư đại tràng, bệnh lý ruột do viêm như viêm loét đại tràng), viêm khớp dạng thấp tiến triển, tình trạng nhiễm trùng nặng, bệnh lupus ban đỏ hệ thống, u lympho, nhồi máu cơ tim, bệnh lý viêm của tiểu khung chung, viêm động mạch tế bào khổng lồ, lao tiến triển;
-Theo Hội tim mạch Mỹ cho biết chỉ số CRP có liên quan đánh giá đến mức nguy cơ tim mạch:
+Nếu hs-CRP < 1 mg/L: Nguy cơ thấp
+Nếu hs-CRP từ 1- 3 mg/L: Nguy cơ trung bình
+Nếu hs-CRP > 3 mg/L: Nguy cơ cao

H14
Các yếu tố ảnh hưởng đến kết quả CRP
-Âm tính giả do dùng các thuốc kháng viêm non-steroides, aspirin, corticosteroid, nhóm thuốc hạ mỡ máu statin, thuốc chẹn beta giao cảm;
-Dương tính giả do dùng các thuốc điều trị hormon thay thế, thuốc ngừa thai, đặt dụng cụ ngừa thai trong tử cung, gắng sức thể lực quá mạnh, có thai, béo phì ₪.